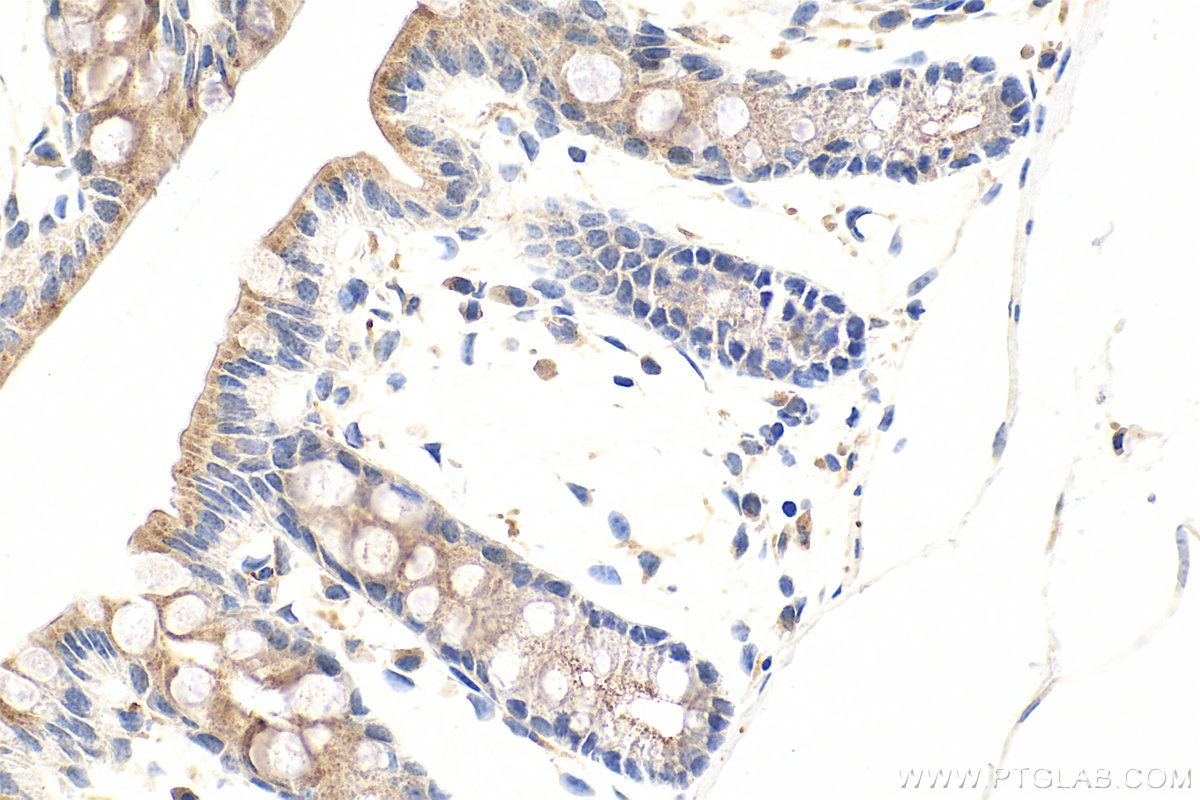
Immunohistochemistry (IHC) staining of mouse colon tissue using TOLLIP Polyclonal antibody (11315-1-AP)

Tested Applications
| Positive WB detected in | HepG2 cells, HEK-293 cells, human liver tissue, mouse brain tissue, PC-3 cells, rat brain tissue |
| Positive IP detected in | PC-3 cells |
| Positive IHC detected in | human gliomas tissue, mouse colon tissue Note: suggested antigen retrieval with TE buffer pH 9.0; (*) Alternatively, antigen retrieval may be performed with citrate buffer pH 6.0 |
| Positive IF/ICC detected in | U2OS cells |
Recommended dilution
| Application | Dilution |
|---|---|
| Western Blot (WB) | WB : 1:5000-1:50000 |
| Immunoprecipitation (IP) | IP : 0.5-4.0 ug for 1.0-3.0 mg of total protein lysate |
| Immunohistochemistry (IHC) | IHC : 1:50-1:500 |
| Immunofluorescence (IF)/ICC | IF/ICC : 1:50-1:500 |
| It is recommended that this reagent should be titrated in each testing system to obtain optimal results. | |
| Sample-dependent, Check data in validation data gallery. | |
Published Applications
| KD/KO | See 8 publications below |
| WB | See 22 publications below |
| IF | See 5 publications below |
| IP | See 2 publications below |
| CoIP | See 3 publications below |
Product Information
11315-1-AP targets TOLLIP in WB, IHC, IF/ICC, IP, CoIP, ELISA applications and shows reactivity with human, mouse, rat samples.
| Tested Reactivity | human, mouse, rat |
| Cited Reactivity | human, mouse, rat, pig |
| Host / Isotype | Rabbit / IgG |
| Class | Polyclonal |
| Type | Antibody |
| Immunogen |
CatNo: Ag1864 Product name: Recombinant human TOLLIP protein Source: e coli.-derived, PGEX-4T Tag: GST Domain: 1-274 aa of BC012057 Sequence: MATTVSTQRGPVYIGELPQDFLRITPTQQQRQVQLDAQAAQQLQYGGAVGTVGRLNITVVQAKLAKNYGMTRMDPYCRLRLGYAVYETPTAHNGAKNPRWNKVIHCTVPPGVDSFYLEIFDERAFSMDDRIAWTHITIPESLRQGKVEDKWYSLSGRQGDDKEGMINLVMSYALLPAAMVMPPQPVVLMPTVYQQGVGYVPITGMPAVCSPGMVPVALPPAAVNAQPRCSEEDLKAIQDMFPNMDQEVIRSVLEAQRGNKDAAINSLLQMGEEP Predict reactive species |
| Full Name | toll interacting protein |
| Calculated Molecular Weight | 30 kDa |
| Observed Molecular Weight | 30 kDa |
| GenBank Accession Number | BC012057 |
| Gene Symbol | TOLLIP |
| Gene ID (NCBI) | 54472 |
| RRID | AB_2256373 |
| Conjugate | Unconjugated |
| Form | Liquid |
| Purification Method | Antigen affinity purification |
| UNIPROT ID | Q9H0E2 |
| Storage Buffer | PBS with 0.02% sodium azide and 50% glycerol, pH 7.3. |
| Storage Conditions | Store at -20°C. Stable for one year after shipment. Aliquoting is unnecessary for -20oC storage. 20ul sizes contain 0.1% BSA. |
Background Information
TOLLIP (Toll interacting protein), is an inhibitory adaptor protein. Tollip is a negative regulator of IL-1R and Toll-like receptors signalling pathway, involved in inflammatory immune response and inhibiting IRAK1 phosphorylation and kinase activity (PMID:11441107, PMID:10854325, PMID:11751856). The TOLLIP-dependent selective autophagy pathway plays a role in clearance of cytotoxic polyQ proteins aggregates (PubMed:25042851).
Protocols
| Product Specific Protocols | |
|---|---|
| IF protocol for TOLLIP antibody 11315-1-AP | Download protocol |
| IHC protocol for TOLLIP antibody 11315-1-AP | Download protocol |
| IP protocol for TOLLIP antibody 11315-1-AP | Download protocol |
| WB protocol for TOLLIP antibody 11315-1-AP | Download protocol |
| Standard Protocols | |
|---|---|
| Click here to view our Standard Protocols |
Publications
| Species | Application | Title |
|---|---|---|
Autophagy TOLLIP-mediated autophagic degradation pathway links the VCP-TMEM63A-DERL1 signaling axis to triple-negative breast cancer progression | ||
PLoS Pathog The MGF300-2R protein of African swine fever virus is associated with viral pathogenicity by promoting the autophagic degradation of IKKα and IKKβ through the recruitment of TOLLIP | ||
J Virol African Swine Fever Virus L83L Negatively Regulates the cGAS-STING-Mediated IFN-I Pathway by Recruiting Tollip To Promote STING Autophagic Degradation | ||
mBio The Globular C1q Receptor Is Required for Epidermal Growth Factor Receptor Signaling during Candida albicans Infection.
| ||
Autophagy A bacterial RING ubiquitin ligase triggering stepwise degradation of BRISC via TOLLIP-mediated selective autophagy manipulates host inflammatory response | ||
Zool Res TAX1BP1 and FIP200 orchestrate non-canonical autophagy of p62 aggregates for mouse neural stem cell maintenance |